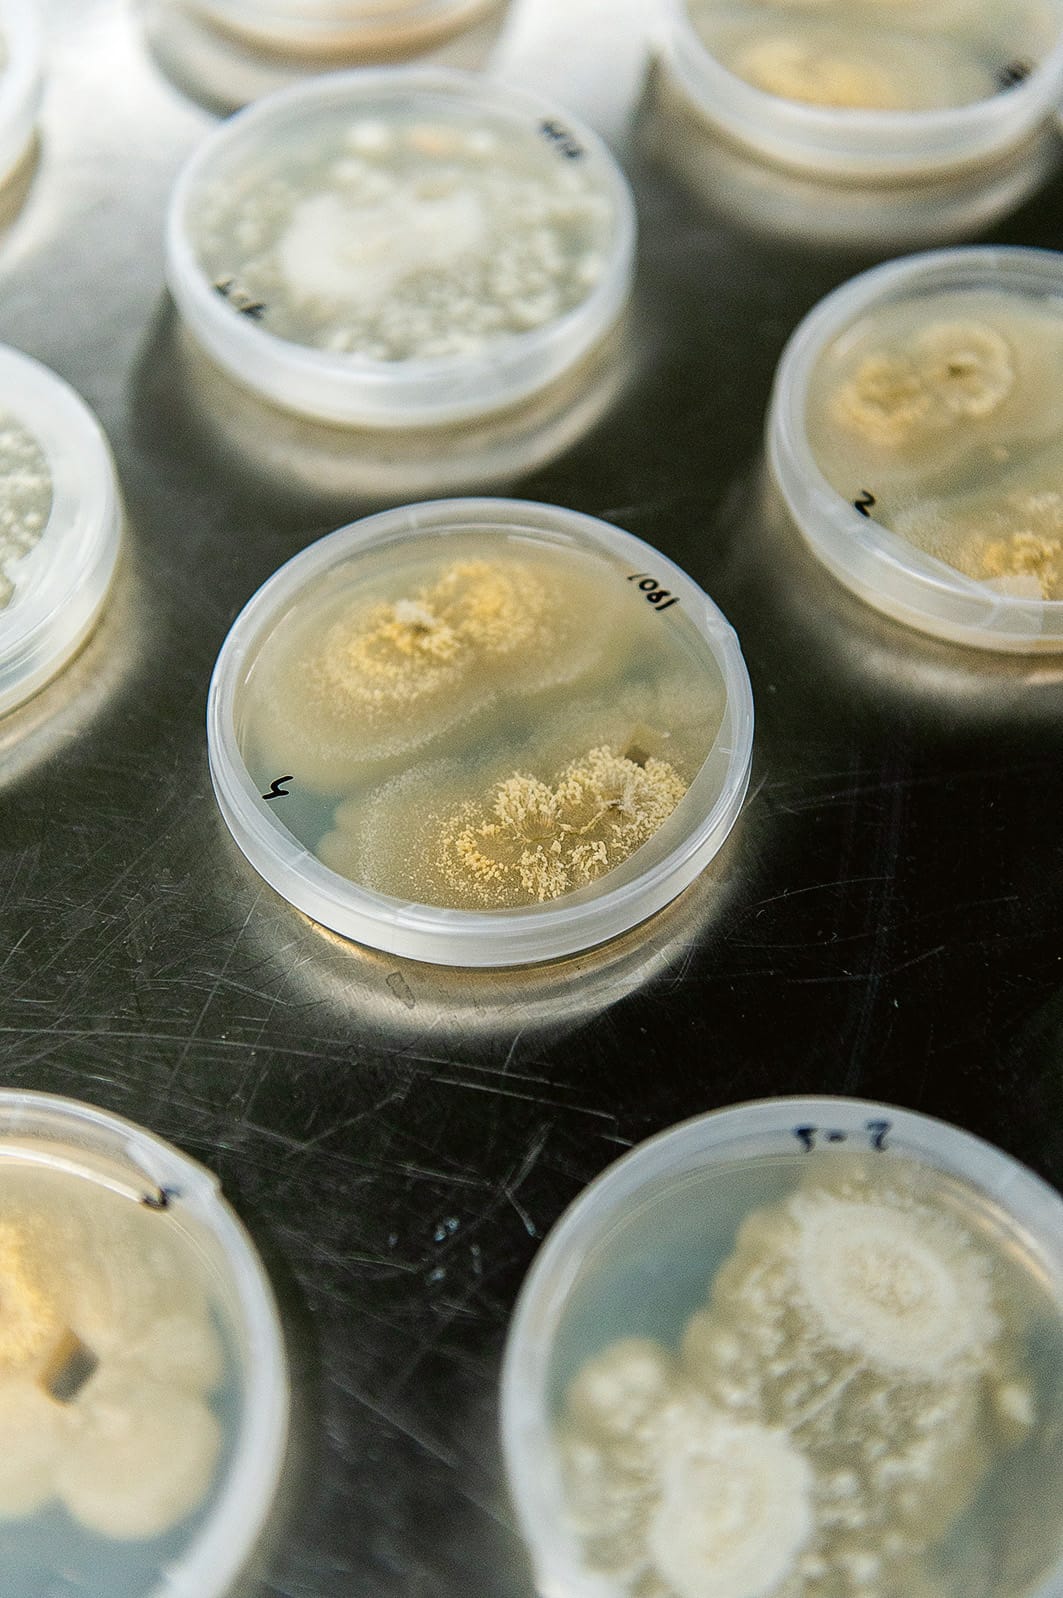

From farmers to marine biologists to Indigenous owners, these biotech inventors are resourceful to the bone.
Words Olivia Congdon
Whether learned or innate, resourcefulness is essential to rural and remote life. “I think there is something to be said about farming that it gives you creative thinking skills, because everyone I know spends their whole day problem-solving,” says farmer, academic and entrepreneur Dr Bronwyn Darlington. She’s the CEO and founder of Agscent, a burgeoning biotech company based on a 2000-hectare cattle and sheep farm at Carwoola, on the New South Wales southern tablelands, just south of Canberra.
Darlington’s quest sounded simple: how to quickly detect a cow pregnancy. Yet the usual method hasn’t changed in more than a hundred years; it involves a qualified vet, some very long gloves and an uncomfortable cow. There had to be a better way, she reasoned, as preg-testing season on the farm rolled around again.
The answer was blowing in the wind. Darlington invented a device that collects the breath of cows – and now other animals, too – and she gathered a team to integrate it with NASA technology. The resulting Agscent Breath diagnostic device can detect a cow’s pregnancy at day 18 after insemination.
Darlington, who also lectures in technological innovation at the University of Sydney, joins me over Zoom from her farm office. Most of the multidisciplinary Agscent team, including scientists, product developers and operations staff, live and work on the property.
She shows me the breathalyser contraption, which looks like a round remote control with a funnel at one end and a bag to contain the cow breath at the other. With this device, any cattle handler can test a cow’s breath on the spot. Importantly, it’s non-invasive. “That low-stress treatment of animals, that’s better for them,” says Darlington. “It’s much better for people who work with them. And it creates a better product.”

The company grew from ambitious yet humble beginnings, involving an unlikely marriage of expertise in agriculture and space missions to Mars. “I was frustrated to the billy-o about how all the money goes to other sectors and yet we are trying to feed the world,” recalls Darlington. “I thought, where’s the money going? The space mission.”
She discovered the missing piece of the puzzle while perusing the NASA website: a patent for nanosensor technology that detects harmful chemicals on the International Space Station. Many emails and meetings later, Darlington found herself at NASA’s Ames Research Center in Silicon Valley during peak Covid lockdowns, exchanging bags of cow breath via car boots with a NASA scientist. Lab analysis of that breath proved a discernible difference in the molecules of pregnant and non-pregnant cow breath. It was a breakthrough.
Agscent is expanding its diagnostic capacity to a suite of devices that will map bovine disease and track methane emissions. The company’s first product is in use on Australian farms with others to follow soon, and there’s strong interest from the US dairy industry.
“Ideally, we’ll then see how we can get to robotics and remote sensing that can make production more efficient and profitable,” Darlington says.
The planet is covered by a fine crust of precious soil that supplies about 95 per cent of the food we eat, Dr Tegan Nock tells me. Farmers such as her are acutely aware of the precariousness of the living systems they rely on. And, like many around her, she has been hunting for better tools to care for the soil.
Nock is co-founder and COO of Loam Bio, a groundbreaking carbon sequestration company based in Orange, central west New South Wales. She was one of five passionate local farmers who started the biotech venture in 2019, and that grassroots origin story runs through everything Loam Bio does. “One of our values is: critique it like an academic, fix it like a farmer,” says Nock, whose career has straddled both worlds – as a grains and livestock farmer and a plant scientist.

Loam Bio responds to two problems: firstly, how to reduce excess carbon that is exacerbating climate change; and secondly, how to reliably lock more carbon into the soil to improve crop quality. “So we banded together around this technology that lets us bridge atmospheric carbon with soil carbon, and store that in a way that it’s useful for the environment and useful for farmers,” Nock says.
The Loam Bio team unearthed (literally) the soil-improvement tool they’d been searching for – a seed treatment dubbed CarbonBuilder. The team selected and cultivated specific microbial fungi that will live in plant roots and fix soil carbon in a stable way. Nock says the treatment builds soil carbon levels, rather than just maintaining them. Plus, farmers can use CarbonBuilder to source additional income from carbon credit schemes.
“It’s not a small feat to take a fungi in a lab to a packet of fungal spores in a farmer’s hand,” Nock says. “There’s years and years and millions and millions of dollars’ worth of R&D that goes into that packet.”

Left Fungal spores live in plant roots and lock in carbon. Photography by Monique Lovick. Right Photography by Rachael Lenehan.
Loam Bio’s home town of Orange is developing as a hub for tech innovation. Nock says this growing community – which includes SparkLabs Cultiv8 and Cauldron – diminishes the challenges posed by distance from city infrastructure, including access to supply chains, support networks and talent recruitment.
Loam Bio now has more than 125 staff in four countries, though about 60 per cent remain in Australia. “We have this incredible team,” Nock says. “We’ve got soil scientists and mycologists who are some of the best in the world. It’s just really cool that a regional business has been able to attract young enthusiastic talent like that.”
Patrick Moase holds up an iridescent oyster shell about the size of his hand and explains how the inner shell, or nacre, can be radically repurposed to mend broken bones. “This product is calcium carbonate in its purest form. It just comes from a different location, which is the ocean, as opposed to human bone,” explains Moase, co-founder and CEO of Marine Biomedical, based in Broome in Western Australia’s remote Kimberley region.
Traditionally, bone injury is treated with a bone graft, which means inflicting more bone damage in the surgical process. Synthetic bone substitutes exist, but few share the natural components of bone that promote swift healing.
Moase, a marine biologist who worked in aquaculture for about 20 years, joined forces with Minghao Zheng, Professor of Orthopedic Research at the University of Western Australia, to figure out how to transform leftover oyster shell, a natural waste byproduct of the pearling industry, into a bone substitute. They ground the shell’s nacre into a fine powder and developed a putty that can fill a void in an injured bone.
The product, named PearlBone, harnesses the natural biomineralisation process of the oyster so the product reabsorbs into the bone as it heals. In preclinical trials comparing PearlBone to conventional treatments, it healed more quickly in the early stages.

“Every now and then things dawn on me, and it’s a bit of a hit in the face that we’re actually doing this in the regions,” Moase says. Among the challenges was creating a specialised clean-room facility, which had to be built off-site and dropped in beside the existing Broome laboratory.
Moase says there’s extra pressure from the community for regional start-ups to excel and do it sustainably. “When you go to the regions and you pioneer something, everyone looks at you as being a case study to help promote the development and diversification in the region.”
The team at Marine Biomedical hopes to have PearlBone ready for regulatory approval by the end of 2024. More than anything, Moase looks forward to the day when his co-founder, Professor Zheng, can use the invention on his own operating table. “There probably aren’t too many surgeons who can walk around and say: I developed an orthopedic device, and I’m also using it.”
Beyond PearlBone, Moase can see plenty of opportunity in repurposing waste from aquaculture. “We are only at the tip of the iceberg of what we want to do,” he says. “But small steps.”
In the red desert of north-west Queensland, near Camooweal, a biotech enterprise is integrating tens of thousands of years of traditional plant knowledge with the latest chemical nanotechnology.
The sandy outback landscape is dotted with endless clumps of spinifex grass, a tussock endemic to Australia. Spinifex is tough stuff – it’s strong, flexible and can survive the extremes of drought and fire. First Nations people have long known of its versatility. “Spinifex grass is an ancient and sacred material to the Indjalandji-Dhidhanu people,” says Indjalandji-Dhidhanu elder Colin Saltmere. “It is also a material we use all the time. Our traditional uses include building shelters and using resin from the grass as an adhesive to attach spearheads and seal water vessels.”

Saltmere, an Adjunct Associate Professor in the University of Queensland’s School of Architecture, Design and Planning, brought the amazing properties of spinifex grasses to the attention of scientists at his university about 16 years ago. It resulted in the use of spinifex fibres in reinforcing rubber and latex products, and more commercial uses are in the pipeline with a new spin-off company.
Called Trioda Wilingi, which means “special grass”, the company is developing injectable medical gels to treat osteoarthritis, and to aid drug delivery and cosmetic treatments. These spinifex-derived gels are less likely to contain allergens, it’s believed, and have a longer shelf-life than those currently on the market.
The UQ scientists behind this development discovered that the cellulose nanofibres of spinifex – the plant’s minuscule building blocks – are as flexible and extraordinarily strong as the whole plant. That, and their unique ability to retain water, makes these nanofibres perfect for use in injectable medical gels, allowing the gel to flow easily through a needle.
The core product is renewable and sustainable, and so is the business model, says Saltmere. “Trioda Wilingi is an example of a marketable product that can be farmed in remote Australia to create new industries and employment opportunities.” Trioda Wilingi is a majority Indigenous-owned company, which employs Indjalandji-Dhidhanu rangers to harvest and pulp the grass before it’s transported to Brisbane for extraction of the nanofibres.
It’s taken years of R&D to this point. Work on commercial uses for spinifex grasses began with a partnership of Trioda’s parent company, Bulugudu Ltd, and the University of Queensland in 2007, boosted by an Australian Research Council discovery grant. Now Trioda Wilingi is focused on finetuning research and safety testing before it goes to market. The venture shows that regional teams can innovate in ways that are sustainable, pioneering and build futures for communities in remote Australia. “Spinifex is a sacred thing,” says Saltmere. “It belongs to Country, and to us – that’s what ‘sacred’ means.”